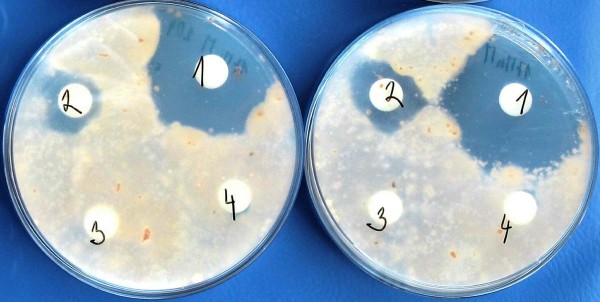
Obr. 2: Microdochium nivale po aplikaci prochlorazu (1) a Serenade (2); varianty 3 a 4 jsou kontrola (voda) Obr. 2: Microdochium nivale po aplikaci prochlorazu (1) a Serenade (2); varianty 3 a 4 jsou kontrola (voda)
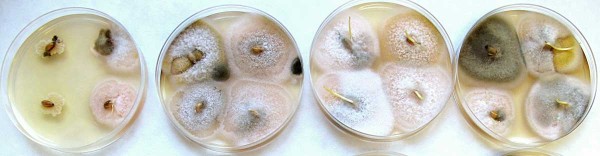
Obr. 3: Sklizené zrno na Petriho miskách; před kultivací na Petriho miskách bylo na zrna vlevo aplikováno 5 μl Serenade Obr. 3: Sklizené zrno na Petriho miskách; před kultivací na Petriho miskách bylo na zrna vlevo aplikováno 5 μl Serenade

Využití biologické ochrany v produkci rostlin
21. 05. 2020 Ochrana obecně Zobrazeno 2652x
Ochrana plodin proti působení biotického stresu je stále jednou z klíčových otázek zemědělství. Po érách nadbytečných a často i neúčelných plošných aplikací chemických přípravků jsou v současnosti metody integrované ochrany rostlin zaměřeny na efektivnost, zkvalitnění pěstovaných plodin, ochranu necílových organizmů a udržitelnost. Pro splnění těchto požadavků se biologická forma ochrany jeví jako ideální varianta, nicméně stále objevujeme její potenciál.
Biologická ochrana je soubor technologií, postupů a principů zaměřených na využívání přirozených nebo přírodních mechanizmů v rámci ochrany rostlin. Vědní obor zabývající se touto problematikou se zformoval v první polovině 20. století. Kromě legislativních záležitostí klade plošné využití biologických přípravků důraz na znalosti interakcí organizmů, rostlinolékařství, fytofarmacii, včetně životních cyklů chorob a využívaných organizmů, etologii, ekologii a další.
V současné době se tento typ ochrany rostlin zdá být plnohodnotnou alternativou standardní „chemické“ ochrany. Nejčastěji je biologická ochrana využívána v systémech ekologického pěstování plodin, ale některé typy a metody lze nalézt i v konvenční produkci.
Stejně jako využití chemických přípravků i produkty biologické ochrany mají své silné a slabé stránky. V neposlední řadě je třeba zmínit postoj široké veřejnosti, která pozitivně reaguje na snížení množství aplikovaných pesticidů, které mohou znečišťovat přírodní zdroje, podzemní vodu, mohou zasahovat necílové organizmy a jsou nebezpečné pro zdraví lidí. Schopnost populace ocenit produkty zemědělství používajícího biologickou ochranu však významně strádá oproti náladě společnosti vůči chemickým přípravkům.
Hlavní rozdíl
Použití chemických přípravků je vázáno řadou pokynů a nařízení, která zjednodušeně řečeno na přítomný patogen nebo škůdce nabízí konkrétní přípravek s jednou či více účinnými látkami a výskyt patogenu tím eliminují, tedy cílený zásah. Jedná se o významný zásah, který je však zároveň silným selekčním faktorem, se všemi důsledky, které tato selekce přináší.
Naproti tomu, opět velmi zjednodušeně řečeno, biologická ochrana předněji působí systémově a nespecificky. Tento způsob zahrnuje i mnohé potenciálně patogenní složky v rovnováze, nedochází tedy k úplné eradikaci, ale ke kontrole jejich populací. V důsledku změny okolních podmínek však může takový „pufrační“ systém selhat a nežádoucí organizmy mohou způsobit významné škody, také efekt aplikace lze pozorovat se zpožděním. Ruku v ruce s biologickou ochranou jde i změna krajiny zahrnující tvorbu menších ploch s jednou plodinou, tvorbu pásů meziplodin, tvorbu remízků, biokoridorů a vodních ploch s cílem plánování produkce na delší časová období jakožto nástroje systémové ochrany nejen proti migraci patogenů.
Definice, terminologie, rozdělení
Biologická ochrana (angl. biological control, biocontrol) je, dle definice, použití mikrobiálních antagonistů k potlačení chorob, ale také použití druhově specifických patogenů na redukci plevele. Pro organizmus potlačující škůdce nebo patogen se používá termín „Biocontrol agent“, případně „bioagens“. V širším kontextu lze takto označit i jakýkoliv produkt metabolizmu zahrnující i jeho fermentovanou podobu, v tomto textu bude termínem bioagens označován pouze živý organizmus.
Funkce biologické ochrany spočívá v inhibici růstu, snižování množství infektivních částic, omezení rozmnožování a šíření jednoho organizmu (patogenu) druhým (bioagens). Významnou měrou zde působí produkce metabolitů, indukce rezistence hostitele, ale také vnášení avirulentních, inkompatibilních nebo nepatogenních mikroorganizmů. Biologická ochrana je i součástí integrované ochrany proti škůdcům a lze do ní zahrnout i veškeré agrotechnické postupy typu rotace plodin, setí a výsadba odolných kultivarů, včetně omezení přítomnosti posklizňových zbytků.
Co se týče živých organizmů, lze v rámci ochrany rostlin proti patogenům rozlišit dva hlavní způsoby: vnášení nepůvodních organizmů a podpora různých složek přirozené populace bioagens. Tuto problematiku provází řada aspektů, které bývají často místně specifické, klíčovou součástí podpory nativních mikroorganizmů je i zjištění příčiny jejich snížené přirozené populace. Uměle introdukovaná bioagens mohou mít problém s osídlením nové niky a vytvářením stabilních (nejen) potravních vztahů, což může být ovlivněno faktory prostředí, počasím, střídáním ročních období, hnojením, obsahem organické hmoty v půdě, kompatibilitou plodin, atd.
Dalším způsobem rozdělení biologické ochrany může být rozdělení na biologicky aktivní látky, redukce škůdců pomocí bezobratlých a obratlovců, a bioagens - tedy bakterie a houby.
Biologicky aktivní látky
Tato kategorie leží na pomezí aplikace cílených chemických preparátů a biologické ochrany pomocí mikroorganizmů. Jedná se však o látky vzniklé působením živých organizmů, rostlin nebo mikroorganizmů, tedy o sekundární metabolity nebo produkty fermentace. V přípravcích se tak využívá obsahu silic a specifických látek, které jsou zkoncentrovány a umožňují jednodušší aplikaci ve formě prášků, postřiků či past. Do této skupiny také patří feromonové lapače a lepové desky pokryté atraktanty.
Skupina biologicky aktivních látek se dále rozděluje podle efektu na biostimulanty, látky indukující růst, regulátory růstu, fungicidy, insekticidy nebo podle typů látky na saponiny, alkaloidy, terpeny, fenoly, peptidy (Bt-toxin), třísloviny a další.
Saponiny a esenciální oleje
V rámci využití biologické ochrany jsou v Zemědělském výzkumném ústavu v Kroměříži testovány látky získané nebo odvozené z rostlin. Jejich struktura i funkce jsou mnohdy unikátní, což může sloužit i jako inspirace pro tvorbu syntetických analogů. Rostliny často ve svých pletivech syntetizují sekundární metabolity, které je chrání před napadení patogeny, případně před okusem zvěří. Tyto přírodní látky mohou být toxické i pro samotnou rostlinu, proto bývají lokalizovány ve vakuolách, v siličných kanálcích a v dalších částech rostliny. Do skupiny látek využívaných v biologické ochraně patří i saponiny, hojně rozšířené sekundární metabolity s velkou strukturní a funkční rozmanitostí. Kombinace hydrofilní a hydrofobní části molekuly snižují povrchové napětí membrán, a tím jsou schopny antimikrobní, antiparazitické a insekticidní aktivity. V siličných kanálcích nebo žláznatých trichomech lze nalézt další významnou skupinu látek - esenciální oleje. Z chemického hlediska jsou esenciální oleje tvořeny směsí diterpenů, fenolů, monoterpenů a seskviterpenů zastoupených v různých poměrech. Přestože jsou esenciální oleje složeny z několika desítek komponent, obvykle obsahují 1–3 látky, které převažují a jsou pro určitý rostlinný druh typické. Např. u bazalky pravé (Ocimum basilicum) tvoří až 88 % z celkového zastoupení složek v oleji estragol u máty (Mentha piperita) 50–60 % mentol a u pomerančovníku (Citrus sinensis) 85 % limonen. Tyto směsi mají také významný fungicidní charakter (obr. 1)

Obr. 1: Ukázka antifungálního účinku 0,1% roztoku oleje z anýzu na potlačení infekce fuzárii (F. culmorum) na osivu pocházejícím z napadených rostlin ozimé pšenice pěstované v laboratorním experimentu; vlevo ošetřeno, vpravo kontrola (voda)
Využití bezobratlých a obratlovců
Nejen v ekologických velkoprovozech, ale i mezi neprofesionálními pěstiteli roste obliba používání dravých roztočů (Typhlodromus pyri, Phytoseiulus persimilis, Amblyseius cucumeris), parazitických vosiček (Encarsia formosa, Aphidius colemani) a hlístic. Pro podporu nativních populací přirozených antagonistů a zvýšení diverzity se využívá tvorby úkrytů, domečků, krytých přístřešků, pastí a dnes oblíbených hmyzích hotelů, k redukci větších škůdců potom stavba bidýlek a dalších úkrytů pro ptáky. V sadařství a vinohradnictví jsou v období před sklizní dravci jednou z nejefektivnějších možností ochrany.
Bioagens
Mikroorganizmy používané v přípravcích na ochranu rostlin jsou často vůči sobě navzájem velmi evolučně vzdálené a schopnost osidlovat prostředí kolem rostlin, ale také uvnitř rostlinných pletiv vznikla nezávisle v průběhu dějin několikrát. Odhaduje se, že průběh změny trofických strategií probíhal z původních patogenních vztahů postupnou změnou z krátkodobé výhodnosti jednoho organizmu vůči druhému na výhodnost dlouhodobou, tedy mutualistickou symbiózu. Důkazem pro to jsou různé formy fakultativních parazitizmů, endofytismu, endosymbiózy a podobně. Pro posouzení vzájemných interakcí bioagens s patogeny, je vhodné zmínit i interakce bioagens s rostlinami, tedy hostiteli.
Symbiotické interakce mezi rostlinami a bioagens
Symbióza znamená soužití dvou a více organizmů. Způsob interakce a vzájemný vliv není vždy přesně definován a mění se v čase. Aplikace biologických agens by měla díky vlastní specifické aktivitě nebo i pasivní přítomnosti přinést pro rostliny pozitivní výsledky. Z praktického hlediska je nejvýhodnější, aby byl použit organizmus schopný reprodukce na stanovišti, rovněž, aby vzájemný vztah s hostitelem byl mutualistický (+,+) a v průběhu času stabilní. Častým typem vztahu je komenzalismus (+,0) nebo neutralismus (0,0). Tyto dva vztahy však bývají časově omezené nebo nejsme schopni pozorovat interakce.
V důsledku komplexity problematiky a snahy o rozdělení mechanizmů působení bude další text zaměřen pouze na způsoby, kterými živé bioagens působí proti houbovým chorobám.
Mykoparazitismus
Mykoparazitismus je formou hyperparazitismu, kdy je patogen atakován specifickým bioagens, poškozujícím přímo mycelium nebo infekční částice. Mezi hyperparazity lze zařadit tzv. hypoviry, fakultativní parazity, obligátní bakteriální patogeny a částečně i predátory. Do kategorie mykoparazitismu lze zařadit i poměrně častý a nespecifický jev - mikrobiální predaci. Typickými zástupci jsou Pythium oligandrum nebo Trichoderma harzianum.
Antibióza
V současné době je známo velké množství mikroorganizmů produkujících antibiotické látky. Tyto látky mohou specificky působit proti konkrétnímu organizmu, většinou jsou však nespecifické. Významnou roli zde hraje citlivost organizmů proti působení těchto látek, produkované množství a vzdálenost cíle efektu.
Produkce metabolitů
Organizmy používané pro biologickou ochranu rostlin také produkují látky z kategorie lytických enzymů, díky kterým mohou rozkládat buněčné molekuly patogenu, jako jsou chitin, proteiny, celulóza, hemicelulóza nebo nukleové kyseliny. Oligosacharidy štěpené z buněk jsou také signálními molekulami indukujícími v rostlinách obranou reakci.
Kompetice
Nepatogenní organizmy žijící uvnitř rostlin nebo v jejich těsném kontaktu chrání před náhlým napadením rostliny případnými patogeny právě v důsledku zabrání stanoviště. V některých případech se můžeme také setkat se strategií, při které kolonizující bakterie vytěsňují svými sekundárními metabolity různé limitní mikroživiny právě z orgánů patogenů, kteří prorůstají do rhizosféry rostliny.
Elicitace obranné reakce rostlin
Obranné reakce rostlin lze rozdělit na dvě základní kategorie.
1. Získaná systemická odolnost, zprostředkovaná pomocí kyseliny salicylové, způsobuje tvorbu specifických proteinů (PR), které lyzují invadující buňky patogenu, také mohou zesílit buněčnou stěnu nebo lokálně indukovat apoptózu vlastního pletiva.
2. Druhým typem obranné reakce je indukovaná systemická odolnost, která je mediovaná kyselinou jasmonovou a ethylenem. Díky působení jasmonátů dochází k produkci alkaloidů a dalších sekundárních metabolitů. Pomocí bioagens lze indukovat obě dvě cesty obranných reakcí.
V současnosti jeden z klíčových mikroorganizmů používaných v biologické ochraně rostlin je grampozitivní aerobní bakterie Bacilus subtillis (jehož kmen QST 713 je součástí přípravku Serenade ASO). Tento mikroorganizmus s českým názvem bacil senný vykazuje fungicidní vlastnosti narušováním buněčných stěn hyf díky produkci látek sekundárního metabolizmu. Tento fungicidní efekt byl posuzován i v laboratořích Zemědělského výzkumného ústavu v Kroměříži (obr. 2 a 3). Bacilus subtillis také produkcí antibiotik působí proti některým bakteriím, např. pseudomonádám. Tvorbou metabolitů rovněž působí proti larvám bázlivce kukuřičného (Diabrotica virgifera). K plejádě efektů lze přidat i indukci obranných reakcí rostlin a syntézu látek podporujících růst (auxinů).
V polních pokusech jsme již několik let sledovali, jakým způsobem co nejlépe využít fungicidního efektu přípravku Serenade ASO. Prověřovali jsme například kombinace s významně sníženou dávkou standardního fungicidu a potvrdilo se, že se jedná o možný způsob snížení celkové pesticidní zátěže prostředí. Při zkouškách využití směsí Serenade ASO a organických olejů se oproti kontrolní variantě významně zvýšila nejen účinnost proti houbovým chorobám, ale zlepšil se fyziologický stav asimilačních orgánů a prodloužila se doba jejich aktivní činnosti (obr. 4).
Obr. 2: Microdochium nivale po aplikaci prochlorazu (1) a Serenade (2); varianty 3 a 4 jsou kontrola (voda)
Obr. 3: Sklizené zrno na Petriho miskách; před kultivací na Petriho miskách bylo na zrna vlevo aplikováno 5 μl Serenade

Obr. 4: Listy ozimé pšenice (Tobak) ošetřené kombinací Serenade ASO + Mero (vlevo) a kontrolní, neošetřené listy (vpravo) ve fázi růstu časné mléčné zralosti
Mykorhizní symbiózy
V Zemědělském výzkumném ústavu v Kroměříži byl v rámci uvedené problematiky v současnosti testován vliv aplikace mykorhizních a endofytických hub na ochranu rostlin proti chorobám přenosným půdou, dále se testuje efekt na zdravotní stav porostu a výnos (obr. 5). Mykorhizní symbiózy jsou evolučně velmi starým vztahem mezi houbami a rostlinami. Do hry vstupuje celá řada faktorů, při jejichž optimální konstelaci přináší rostlinám výrazné pozitivní efekty. Těchto efektů stabilizace společenstva dochází především v trvalých porostech, přesto při vhodném postupu lze těžit i z efektů, které přináší raná kolonizace, například indukce obranných reakcí.
Letošní výsledky jsou značně ovlivněné přítomností škůdců, proto jsou posuzovány pouze některé z parametrů, a to hodnocení napadení stéblolamem (Oculimacula spp; obr. 6; graf 1) nebo schopnost přežití vnášených izolátů (tab. 1).
Graf 1: Hodnocení stupně a četnosti napadení stéblolamem (Oculimacula spp.) na pšenici seté var. Bohemia (Triticum aestivum) vyjádřené IN číslem dle Scotta a Hollinse

Obr. 5: Kolonizace kořene arbuskulární mykorhizní houbou; úsečka značí 200 μm, hvězdičkou jsou označeny útvary mykorhizní houby zvané vezikuly, barveno trypanovou modří

Obr. 6: Báze rostlin pšenice napadené stéblolamem (Oculimacula spp.).
Závěr
Některé z výsledků stojí za povšimnutí a otevírají další možnosti výzkumu a testování. Znalost postupů a aplikace biologicky aktivních látek, případně mikroorganizmů schopných pozitivních efektů vůči rostlinám nám dává naději k trvale udržitelnému rozvoji zemědělství nejen v našich klimatických podmínkách.
Mgr. Dominik Bleša, Mgr. Pavel Matušinský, Ph.D., Dr. Ing. Ludvík Tvarůžek, Mgr. Ivana Svačinová, Ing. Simona Růžková, Ing. Markéta Hambálková; Agrotest fyto, s. r. o., Kroměříž
Další články v kategorii Ochrana obecně











RSS
RSS